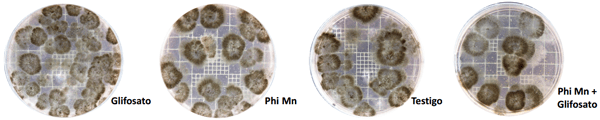

Efecto del glifosato y del fosfito de manganeso sobre la intensidad de ataque de macrophomina phaseolina en plantas de soja
Publicado: 27 de septiembre de 2016
Fuente: Elesgaray Agustina Maria, Natalia Tobar Gomez, Seijas C. S. (Cátedra de Fitopatología), Federico Spagnoletti (Cátedra de Microbiología) , Marcelo Carmona. Facultad de Agronomía, Universidad de Buenos Aires (UBA). Argentina.
Introducción
El hongo Macrophomina phaseolina es el agente causal de la Podredumbre Carbonosa de la base del tallo, en más de 500 hospedantes, incluido el cultivo de soja. El glifosato es el herbicida más utilizado en la historia de la agricultura. La relación entre el glifosato y los patógenos habitantes del suelo es controversial. Los fosfitos (Phi) son sales derivadas del ácido fosforoso que parecen ser activadores de las defensas vegetales.
Objetivos
Analizar el efecto de la aplicación de Phi Mn, Glifosato y la combinación de ambos, in vivo sobre plantas de soja inoculadas artificialmente con M. phaseolina, sobre la intensidad de la enfermedad.
Materiales y Métodos
Se llevaron a cabo ensayos in vivo en invernáculo, en macetas. Se utilizó un diseño completamente aleatorizado con un arreglo factorial de tres factores: Patógeno, Phi Mn (Plus Ultra Mn®) y Glifosato (Total Super®). Antes de la siembra, se inoculó el patógeno en el sustrato, mediante el agregado de granos de arroz colonizado a las macetas. A los 60 días (R5), las plantas fueron descalzadas, lavadas, secadas en estufa a 40ºC y molidas. Se determinaron las unidades formadoras de colonia de M. phaseolina por gramo de raíz (UFC/gr.) mediante un método adaptado de Mengistu, et al. (2007) y Reznikov, et. al (2011)
Fotografía 2. Ensayo en invernáculo

Resultados
Figura 1. UFC promedio de M. phaseolina por gramo de raíz para los distintos tratamientos (Letras distintas indican diferencias significativas p< 0,05)

Figura 2. Interacción significativa entre los factores Phi Mn y Glifosato.

Figura 3. UFC/ gr. raíz de M. phaseolina en medio selectivo (Mengistu, et. al 2007) para los distintos tratamientos.

La mayor cantidad de UFC/gr. se obtuvo con el tratamiento con Glifosato (5414 UFC/gr.); seguido por el tratamiento que contenía Phi Mn (4596 UFC/gr.), y el testigo inoculado (4150 UFC/gr.). Una disminución significativa (p< 0,05) de las UFC fue obtenida en el tratamiento combinado de Phi Mn + Glifosato, con 2882 UFC/gr., representando un 47% de control en comparación con el tratamiento de Glifosato y de 30% respecto del testigo inoculado.
Discusión y Conclusiones
La combinación de Phi Mn + Glifosato redujo significativamente la enfermedad. Si bien no se detectaron diferencias significativas entre los demás tratamientos, el Phi Mn fue similar al testigo. La mayor incidencia de enfermedad, representada por la mayor cantidad de UFC/gr. raíz, se obtuvo con el tratamiento Glifosato. Estos resultados indican que podría existir una relación entre el uso del Glifosato y la incidencia de enfermedades en el cultivo de soja, lo que podría enmendarse agregando Phi Mn en mezcla con el Glifosato.
Temas relacionados:
Autores:



Recomendar
Comentar
Compartir
17 de noviembre de 2016
Bom dia amigos Argentinos, gostei muito das opiniões, comentários, dós colegas, gostaria que comentasse em qual fase da cultura o Glifosato poderia causar mais macrophomina? Na dessecação para o plantio da soja onde são usadas doses maiores/ha ou em pôs emergentes vegetativo, ou pôs emergente fase reprodutiva?
Qual sua opinião?
Não aceito dicutir futebol ! Kkkkkk
Recomendar
Responder
29 de octubre de 2016
Anteriormente eu trabalhava no sul do Paraná Brasil, onde o uso de glifosato era usado o mínimo possível, no máximo 2 kg de ativo hectare/ano em 3 cultivos anuais, índice pluviométrico 1800 mm de chuvas anuais, temperaturas média anual de 19 graus, temperatura mínima -2 graus, temperatura máxima 40 graus, com grande produção de palha 25ton/ano, MO de 5% . O problema com a macrophomina era pouco significativo. O uso de fusitil de alumínio era obrigatório para o controle de outra doença em soja chamada de míldio.
Atualmente trabalho no norte do país, em Mato Grosso, chuvas anuais 2400 mm com período de seca 5 meses, temperatura média 30 graus, uso anual de 4000 gramas de ativo Glifosato em 2 cultivos anuais, e com produção de somente 13 ton de palha.
Resultado, macrophomina está destruindo a produtividade de soja no Brasil, enquanto isso os pesquisadores brasileiros estão preocupados somente com nematoides!
Pergunta? Porque não me é permitido mais plantar as variedades convencionais!
Recomendar
Responder
25 de noviembre de 2016
Sera que el Dr Carmona conteste,puede estos fosfitos de Mn contrarrestar incidencias de Fusarium en maní?
Disculpe por ser otro cultivo y género.
Le agradecería.
Slds
Recomendar
Responder


Institut de Recerca I Tecnologia Agroalimentàries (IRTA)
La finalidad del IRTA es contribuir a la modernización, a la mejora y al impulso de la competitividad, al desarrollo sostenible de los sectores agrario, ali
Enlace recomendado
15 de noviembre de 2016
Seria bueno hacer ensayos en campos comerciales y tambien ver el tema de suelos
Felicidades muy buena informacion
Recomendar
Responder
27 de octubre de 2016
opino que los investigadores en este ensayo utilizaron fosfito de manganeso por varias razones entre ellas , el glifosato en suelo tiene la capacidad de quelatar micro nutrientes en especial hierro y manganeso muy fuertemente con constantes ( Ky) equivalente o mayores a los EDTA y estos elementos son clave en la reproducción y transporte de energía de la mayoría de los hongos y bacterias benéficas en suelo , de esta forma el glifosato actúa como un agente " sideroforo" colocando en ventaja micro organismos patogenos que no son tan susceptibles versus los beneficos.
Recomendar
Responder
Recomendar
Responder
26 de octubre de 2016
Excelente trabajo e información. Estos resultados se analizarán también en campo, para tener la comparación puesto que las condiciones de clima en invernadero son diferentes en campo abierto. Los fosfitos más utilizados contra hongos son de K y Ca, podrían tener algún efecto? Gracias.
Recomendar
Responder
6 de octubre de 2016
Pienso que el efecto negativo del glifosato es la consecuencia de su uso tan prolongado e intensivo, que ha logrado crear resistencia en este hongo macrophomina, mientras que con su efecto fungicida impide la competencia de otros hongos benéficos.
Recomendar
Responder
5 de octubre de 2016
Me gustaría saber por que se utilizó Phi Mn y no de K, que es el que mejor comportamiento tienen como fungicida, según lo que he leído últimamente. Muy bueno el trabajo, sigan haciéndolos sencillos y concisos van a tener muchos lectores. ??
Recomendar
Responder


Institut de Recerca I Tecnologia Agroalimentàries (IRTA)
La finalidad del IRTA es contribuir a la modernización, a la mejora y al impulso de la competitividad, al desarrollo sostenible de los sectores agrario, ali
Enlace recomendado
5 de octubre de 2016
Ojalá nos puedan precisar el momento y la dosis utilizada.Asumimos que es soya transgenica.
Recomendar
Responder

¿Quieres comentar sobre otro tema? Crea una nueva publicación para dialogar con expertos de la comunidad.